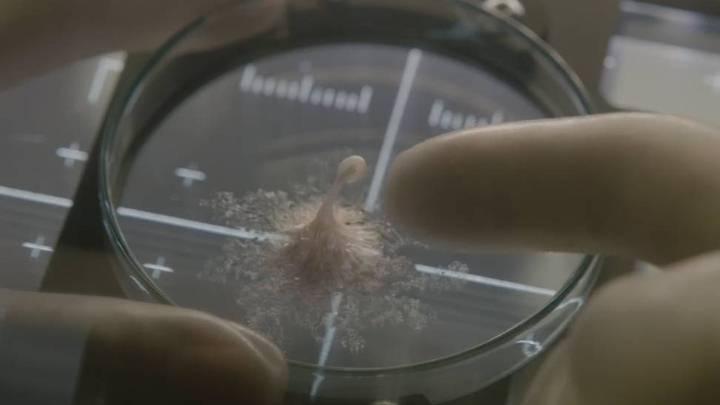
Dangerous Alien Pathogens Could Reach Earth And Humanity Is Not Prepared At All

Ansh Srivastava
 Mystery
4 min
Mystery
4 min
Aliens Created Our DNA and Marked It With The Number 37: Says Kazakhstan Scientists
Ever since the rise of humanity, humans are baffled about their source of origin. It is believed by many that we are not the…
 Mystery
2 min
Mystery
2 min
Marilyn Monroe Murder Conspiracy: Killed Due To Knowledge About Aliens?
Considered the most sensual beauty icon of the 20th century, the story and life of Marilyn Monroe is associated with hundreds of conspiracy theories.…
 Paranormal
2 min
Paranormal
2 min
The Alien Abduction Of Sheera Lumira Rejoice: Ovarian Scarring As Evidence
A video clip by Sheera Lumira Rejoice has been surfacing the internet and it has already gained 3.5 million views as of now. In…
 Mystery
4 min
Mystery
4 min
The Strange Disappearance Of 3000 Chinese Soldiers: Did They Travel To An Alternate Reality?
In 1939, about 3000 soldiers mysteriously disappeared in southern Nanjing. They were prepared to defend the area from the Japanese. Two hours later, an aide reported…
 News
4 min
News
4 min
Beginning Of Space War I: UFOs, Russian Satellite Killers, And U.S. X-37
Is there any possibility of fighting a Space War for us humans? If yes, then who will cause it? Let us commence with the…
 Science
3 min
Science
3 min
Scientists Warns Of Presence Of False Fossils On Mars
Could this unsolicited warning be anticipating, paradoxically, a fossil announcement on Mars? What actually do they mean by false fossils? Let’s find out When…
Science
3 min
Science
3 min
Dangerous Alien Pathogens Could Reach Earth And Humanity Is Not Prepared At All
Before traveling out of the Earth becomes a regular event, the world needs to implement some basic biosecurity measures, Otherwise, we could start receiving unwanted…
 Mythology
3 min
Mythology
3 min
Ancient Civilizations And Sound Waves: Healing Power Of Music
Ancient civilizations used a variety of healing exercises, and one of them was utilizing the benefits of music. Music has never-ending advantages and it…
 Mystery
1 min
Mystery
1 min
A Mysterious Black UFO Captured Over A Volcano In Mexico And Disappeared Into A Vent
Ufologists have long noticed the strange connection between volcanoes and UFOs. UFOs love to fly over volcanoes or fly inside a vent. A strange black…
 Science
9 min
Science
9 min
The Scientist Who Claimed That 22 Billion Aliens Live In Our Solar System
In the 1830s, a church minister and amateur astronomer tried to calculate the number of intelligent creatures in our solar system. More than 180 years…
 Mystery
5 min
Mystery
5 min
The Project Rainbow: Truth Behind the Philadelphia Experiment
The Philadelphia Experiment is one of the most bizarre military urban legends ever, and it has persisted as an infamous World War II conspiracy…
 Mystery
3 min
Mystery
3 min
Terrifying 2022 Predictions By Nostradamus: “A Dangerous Year Ahead”
The apocalyptic panorama that we have been living in recent times may not end in 2022, but quite the opposite, here we have gathered…